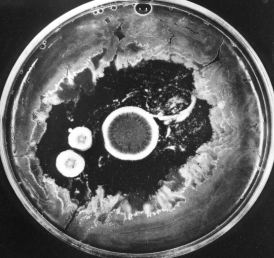

| The photo (courtesy of Merck & Co., Inc.) shows how the growth of bacteria on the agar in a culture dish has been inhibited by the three circular colonies of the fungus Penicillium notatum. The antibiotic penicillin, diffusing outward from the colonies, is responsible for this effect. Today, penicillin is made from cultures of Penicillium chrysogenum that has been specially adapted for high yields. |

These synthetic molecules block the final step in the conversion of PABA to folic acid so they, too, block nucleotide and protein synthesis in bacteria but not in mammals.
Trimethoprim is one of several in current use. These folic acid analogs are often used in combination with a sulfa drug.

The beta-lactams get their name from the characteristic ring structure - shown here in blue - that they all share. (The green arrow shows the bond that is broken by the beta-lactamases that are synthesized by many penicillin-resistant bacteria.)
They include the The beta-lactams all work by interfering with the synthesis of the bacterial cell wall - a structure that is not found in eukaryotes.
The walls of bacteria are made of a complex polymeric material called peptidoglycan. As its name suggests, it contains both amino acids and sugars.
The sugars are of two kinds
The beta-lactams all work by interfering with the synthesis of the bacterial cell wall - a structure that is not found in eukaryotes.
The walls of bacteria are made of a complex polymeric material called peptidoglycan. As its name suggests, it contains both amino acids and sugars.
The sugars are of two kinds

This elaborate, covalently cross-linked structure provides the great strength of the cell wall. It also leads to the remarkable conclusion that the bacterial cell wall meets the definition of a single molecule!
The beta-lactam antibiotics bind to and inhibit enzymes needed for the synthesis of the peptidoglycan wall. While they have little effect on resting bacteria, they are lethal to dividing bacteria as defective walls cannot protect the organism form bursting in hypotonic surroundings.
Examples are:
| Link to discussion of translation. |
| Link to a discussion of the prokaryotic nature of gene expression in mitochondria. |
Macrolides are products of actinomycetes (soil bacteria) or semi-synthetic derivatives of them. They bind the 50S subunit of the bacterial ribosome thus inhibiting protein synthesis.
Erythromycin is a widely-prescribed macrolide.
These relatives of the macrolides also inhibit bacterial protein synthesis by binding to the 50S ribosomal subunit.
Quinupristin and dalfopristin are examples. As of 1 October 1999, they will be sold as a mixture under the tradename Synercid. Combined, they show great promise in treating certain infections resistant to vancomycin - currently the antibiotic of last resort for some hospital-acquired infections.
Ciprofloxacin, norfloxacin and ofloxacin are examples.
They behave as detergents, increasing the permeability of the membranes that encase bacteria and causing the contents of the bacterial cell to leak out.
This semi-synthetic antibiotic binds to the bacterial RNA polymerase and prevents it from carrying out its role in transcription. Its affinity for the equivalent eukaryotic enzyme is much lower.
This antibiotic blocks the action of the bacterial isoleucine tRNA synthetase, the enzyme responsible for attaching the amino acid isoleucine (Ile) to its tRNA in preparation for protein synthesis, so protein synthesis is inhibited. It spares the equivalent eukaryotic enzyme.
Cycloserine inhibits synthesis of the bacterial cell wall but by a different mechanism than the beta-lactam antibiotics discussed above. Cycloserine is an analog of D-alanine and blocks the incorporation of D-alanine into the peptide bridges in the bacterial cell wall (look back). It is derived from an actinomycete.
This product of a streptomyces achieves its effect by interfering with the 30S subunit of the bacterial ribosome. It is particularly effective against the gonococcus, the bacterium that causes the sexually-transmitted disease (STD) gonorrhea.
Glycopeptides also interfere with the synthesis of the bacterial cell wall but by a different mechanism than the beta-lactams.
Vancomycin is a widely-used glycopeptide in the U.S. It binds to the D-alanines on the precursors of the peptidoglycan cross bridges preventing their cross-linking (look back). It has become the antibiotic of last resort as resistance to the other antibiotics has become more and more common.
These new antibiotics, e.g., linezolid (tradename = Zyvox), are still in clinical trials. Early results indicate that they will be effective against many bacteria that have developed resistance to the older antibiotics.
These antibiotics attack a previously-unexploited chink in the bacterium's armor: the proper assembly of the complex of fMet-tRNA with the messenger RNA (mRNA) and the 30S ribosomal subunit. Eukaryotes do not begin translation with fMET.
| Link to discussion of translation. |
None of the antibiotics discussed above is effective against all bacterial pathogens.
Example: In the U.S. in the decade from 1985-1995, resistance of Shigella (which causes gastrointestinal illness) to ampicillin grew from 32% to 67%. And, while only 7% of these isolates were resistant to the combination of sulfamethoxazole and trimethoprim at the start of the decade, that figure had grown to 35% by the end of the decade.
Bacteria develop resistance by acquiring genes encoding proteins that protect them from the effects of the antibiotic. In some cases the genes arise by mutation; in others, they are acquired from other bacteria that are already resistant to the antibiotic. The genes are often found on plasmids which spread easily from one bacterium to another - even from one species of bacterium to another.Examples:
An alarming number of human pathogens have acquired genes to combat all the presently-used antibiotics except vancomycin and recently vancomycin-resistant bacteria have appeared. These multidrug-resistant strains are particularly common in hospitals where antibiotic use is heavy, and the patients often have weakened immune systems.

Farmers can help as well by avoiding the use of antibiotics in their livestock that are similar to those used in humans. Antibiotics are widely used in healthy livestock to improve their growth rate (by an unknown mechanism).
|
An article in the 20 May 1999 issue of The New England Journal of Medicine documents the recent development of quinolone resistance in Campylobacter jejuni, the most frequent bacterial cause of gastroenteritis in humans. The rise coincides with the approval in 1995 of the use of quinolones by U. S. poultry farmers (chickens also become infected by C. jejuni). Similar recent increases in quinolone-resistant C. jejuni have been reported in Holland and also in Spain (where as many as 50% of human infections are now caused by bacteria resistant to the antibiotic). In each country, the appearance of resistant strains followed the widespread introduction of quinolone treatment for animals. |
Drug companies - after many years of complacency - are now responding to the threat of antibiotic-resistant bacteria. Over a dozen new antibiotics are being developed and some have already reached clinical trials.
Many of these are semi-synthetic modifications of already-existing antibiotics, including newOthers (e.g., linezolid) are entirely new, attacking previously-unexploited chinks in the bacterial armor.
| Welcome&Next Search |